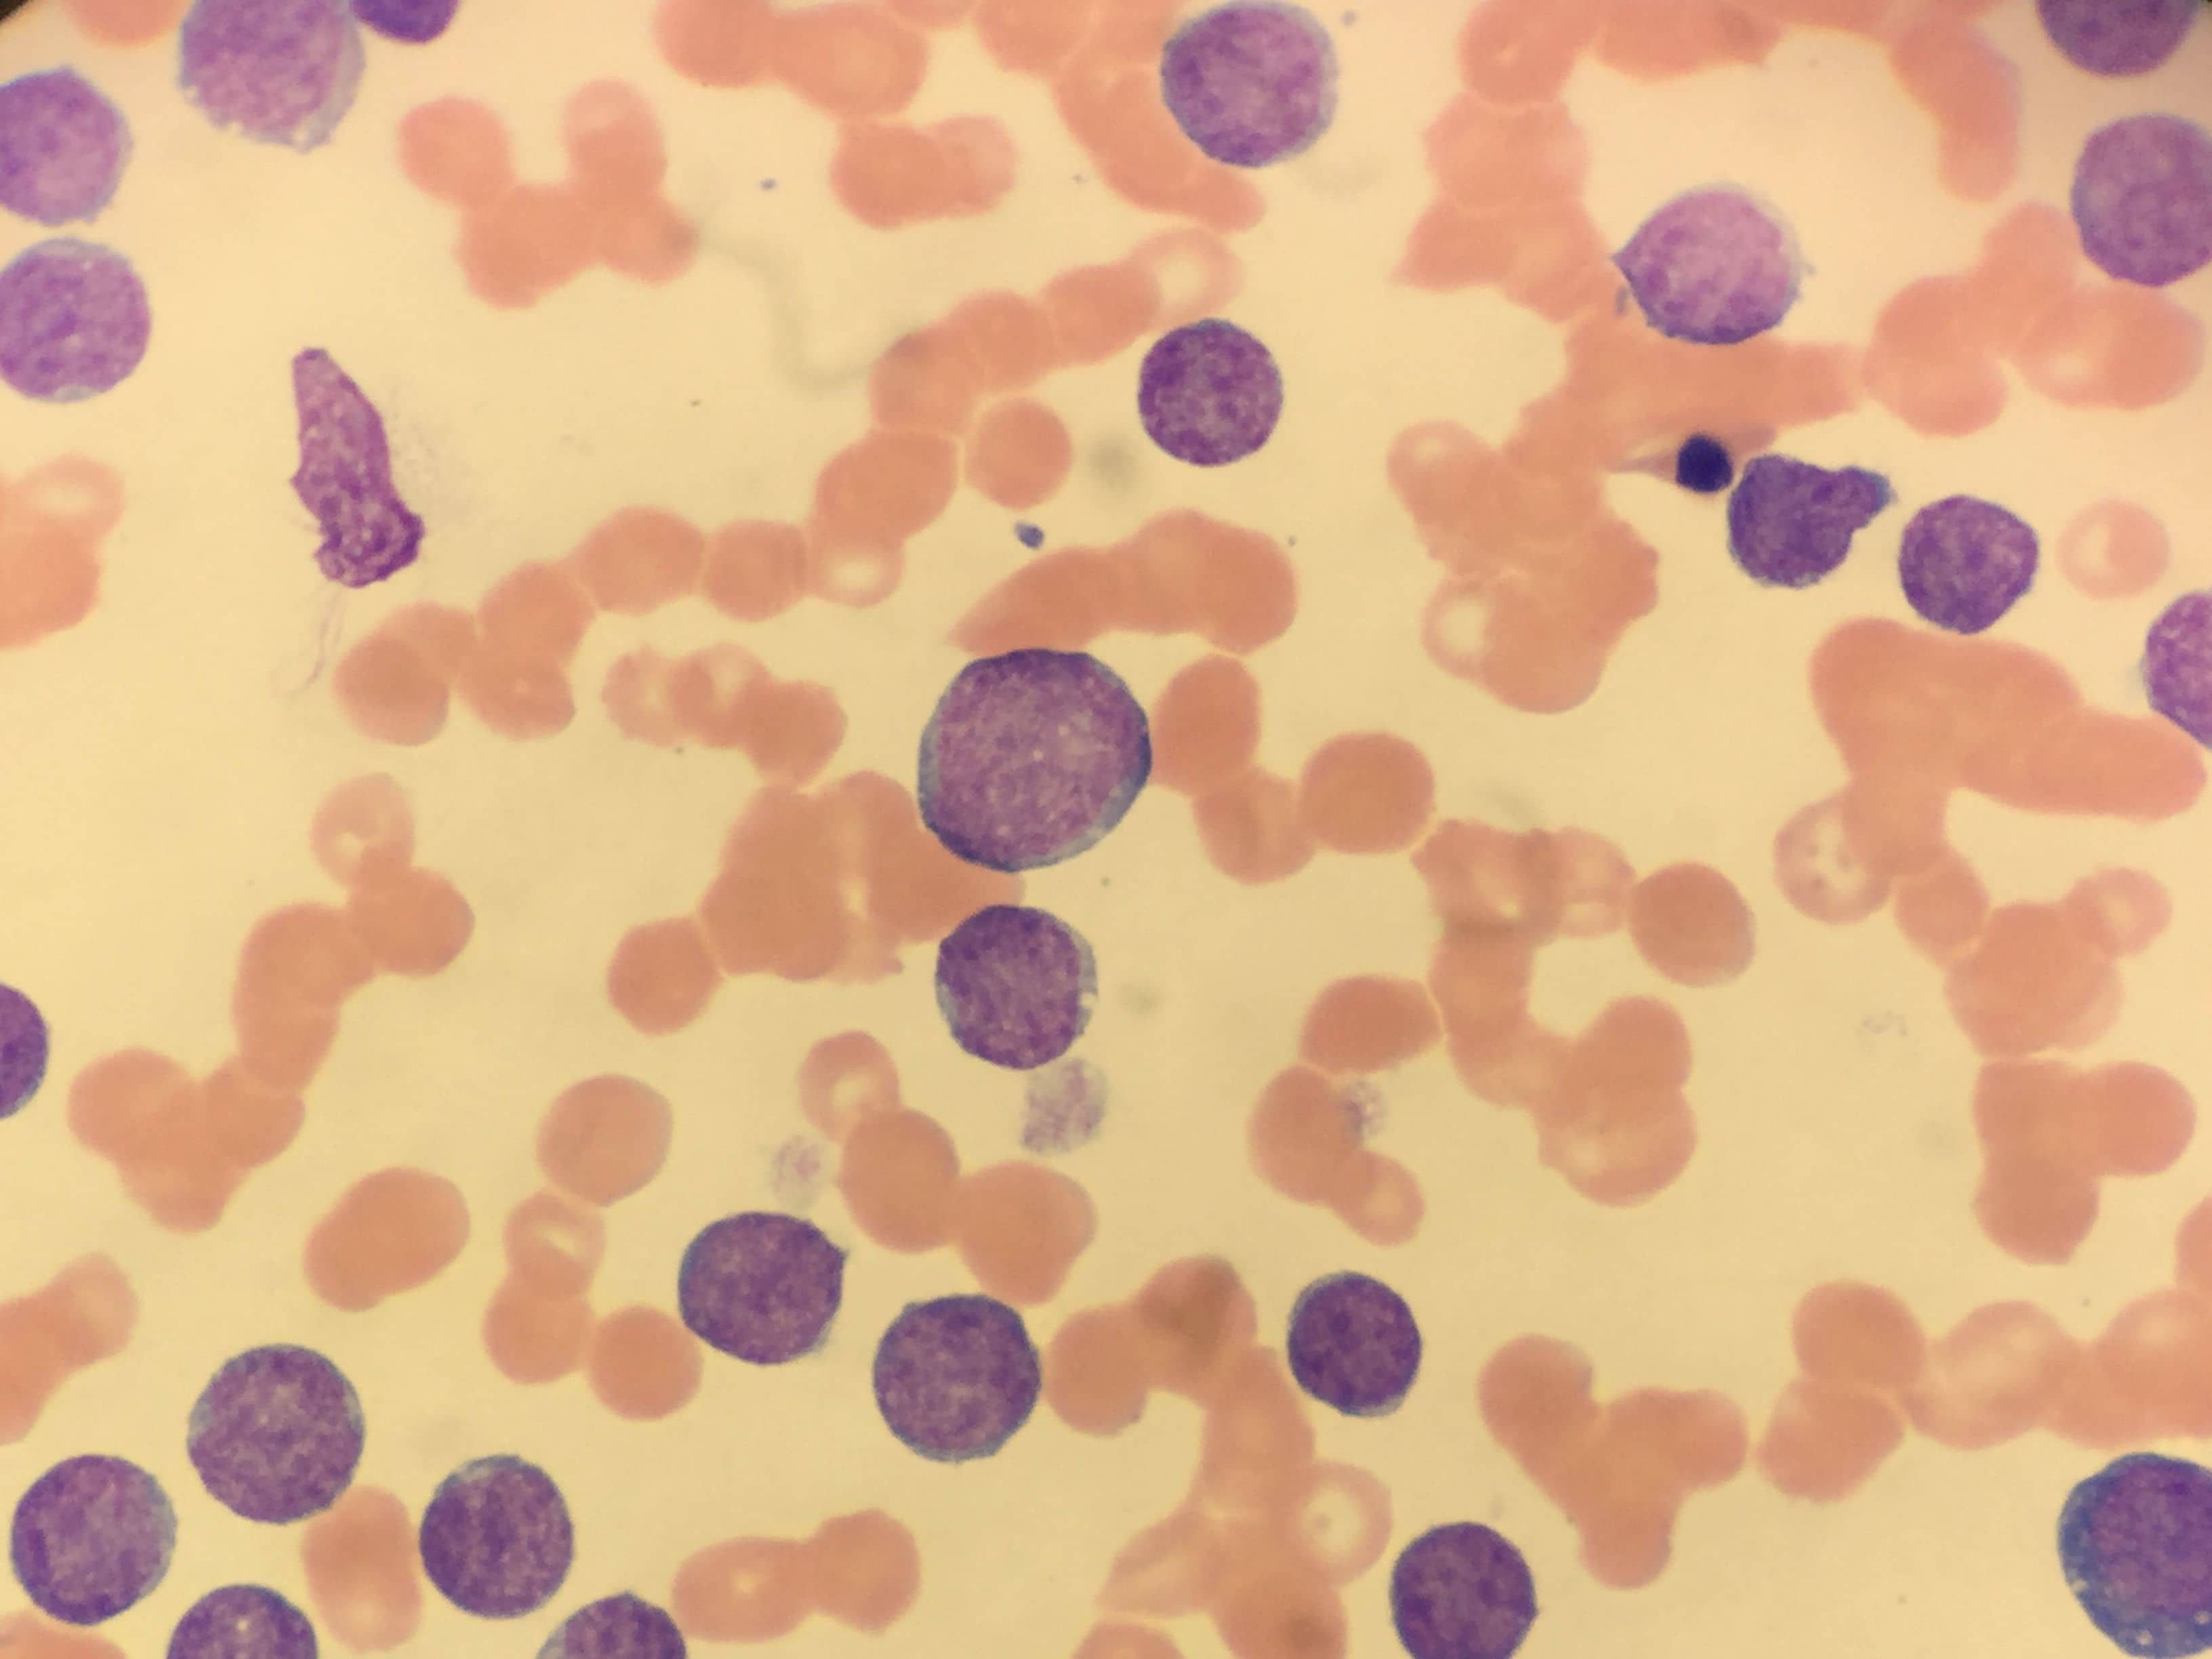

-1.jpg&w=3840&q=70)
Utilisée pour détecter l'amplification du gène HER2 dans les cellules tumorales.
Notre mission est d’améliorer la qualité des soins en fournissant des diagnostics précis et rapides, contribuant ainsi à une meilleure prise en charge des patients.
Contactez nous
Fiabilité des Résultats
Résultats enligne
Diagnostic Précis
Archivage pendant 5ans
Notre mission est d’améliorer la qualité des soins en fournissant des diagnostics précis et rapides, contribuant ainsi à une meilleure prise en charge des patients.
À Propos de Nous
Depuis 2005, notre laboratoire d’anatomopathologie s’engage à offrir des diagnostics précis et fiables pour une prise en charge médicale optimale. Grâce à des technologies de pointe et une équipe d’experts qualifiés, nous analysons des échantillons biologiques avec rigueur et expertise afin d’accompagner médecins et patients dans le processus diagnostique.
.webp&w=3840&q=70)
Nos services
-1.jpg&w=3840&q=70)
Utilisée pour détecter l'amplification du gène HER2 dans les cellules tumorales.

Une technique de laboratoire qui utilise des anticorps marqués par des fluorochromes pour détecter des antigènes spécifiques dans des échantillons biologiques.

L’examen approfondi des tissus et cellules pour détecter des maladies comme le cancer.

Une technique permettant de mesurer précisément la taille des cellules et des structures tissulaires au microscope.

Une mesure utilisée pour évaluer la profondeur d’un mélanome (cancer de la peau). Plus l’indice est élevé, plus le risque est important.

Analyse des cellules prélevées par frottis (comme le test Pap pour le col de l’utérus) ou par aspiration d’un liquide.

technique de prélèvement qui permet d’extraire un petit fragment de tissu à l’aide d’une aiguille fine, afin d’analyser sa structure au microscope.

Un petit échantillon de tissu est prélevé (par seringue, endoscopie ou chirurgie) pour être analysé au microscope.

une technique qui utilise des anticorps spécifiques pour détecter des antigènes particuliers dans les tissus.

Un prélèvement réalisé à l’aide d’une fine aiguille pour analyser des cellules provenant d’un nodule ou d’une masse suspecte (ex. thyroïde, sein, ganglions).
Résultats En ligne
Consultez vos analyses en toute sécurité, où que vous soyez et à tout moment.

Actualités
Restez informé des dernières avancées en anatomopathologie.


.jpg&w=3840&q=70)
Votre avis, notre engagement
-1.png&w=3840&q=70)
Rabah Guidoum
Un bon accueil à la hauteur de la renommée, personnel à l'écoute, fiabilité des résultats et respect des délais, Rabbi yahfdhhom

Abdenour Abdel
Le laboratoire offre un excellent service client, des résultats rapides et des analyses fiables.
-1.png&w=3840&q=70)
Djassim mus
Une équipe tres motivée qui aime leurs travail et tres responsables pour le bien des patients. Des résultats a l'heure avec une bonne fiabilité et consciences professionnel. La responsable que je l'admire énormément pour sa présence au bien des patients.
-1.png&w=3840&q=70)
Sid ahmed Mechtour
Le personnel est très accueillant, chaleureux et respectueux . J'ai adoré leur service de qualité et leur grand professionnalisme. Je le conseille fortement ...
Contactez-nous
Vous avez une question ou vous souhaitez tout simplement déposer votre candidature? Remplissez ce formulaire.
Samedi - Jeudi:
8:00–17:00
02, Rue Hacene, Rue Achour Hassane,
Bab el oued, Alger
Formulaire de contact
Questions fréquentes